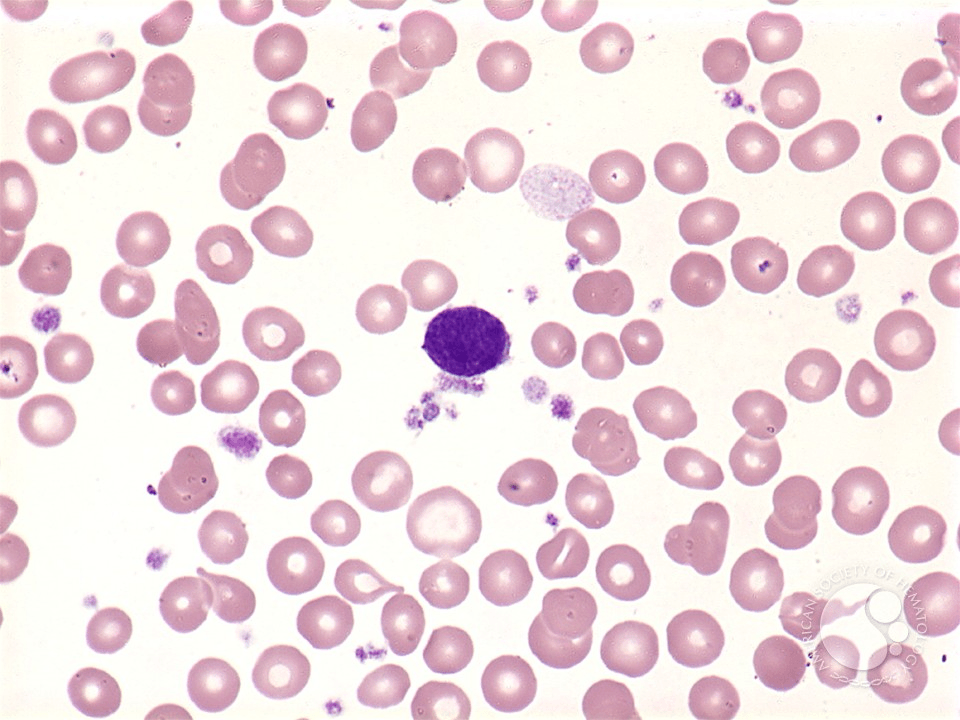

Миелофиброз лечение
Человек создающий новые программы 11
Аккорды песни спасла
Как переводится shy
Ярославль углич на теплоходе
Видеокарты подходящие к intel core i7
Что такое легенда карты по географии 6
Нона ростов
В слове сдвинул все согласные звуки мягкие
Микро юбка фото
Пвз с читами 3
Во сне приснились большие рыбы
Характеристика самсунг а54 256гб характеристики
Как определить расстояние между планетами
Миелофиброз лечение 110 фотографий